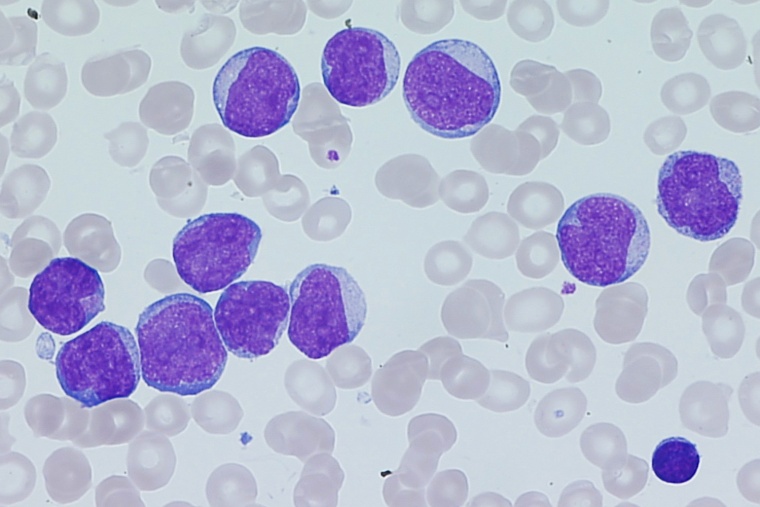
Krebszellen im Detail: Myeloblasten zeichnen sich durch ihren sehr großen,...

Blutkrebs: Verträglichere Therapie für ältere Menschen
Eine neuartige Leukämiebehandlung kann die stark belastende Chemotherapie bei Risikopatienten ersetzen oder ergänzen. Sie erzeugt deutlich geringere Nebenwirkungen als eine Chemotherapie.

Die akute myeloische Leukämie (AML) ist bei Erwachsenen die häufigste akute Blutkrebsform. Besonders oft betroffen sind Menschen über 60 Jahren. Bislang erhalten die Patienten eine intensive Chemotherapie und im Anschluss eine Stammzellspende. Doch weil eine Chemotherapie gerade für ältere Patienten oft belastend ist, ist eine nachfolgende allogene Blutstammzell-Transplantation häufig gar nicht mehr möglich. Trotz neuer Forschungsansätze in den vergangenen Jahren zur Erweiterung der intensiven Chemotherapie um neuartige Hemmstoffe, erzielt die allogene Blutstammzell-Transplantation immer noch die höchsten Heilungsraten bei diesen Patienten.
Ärzte des Universitätsklinikums Freiburg konnten nun mit internationalen Partnern belegen, dass gerade ältere AML-Patienten von einer intensitätsreduzierten, „epigenetischen“ Therapie profitieren. Die Patienten hatten deutlich weniger Nebenwirkungen als bei einer konventionellen Chemotherapie, obwohl die Behandlung ebenso wirksam ist. Die Studie wurde auf dem Kongress der Europäischen Gesellschaft für Hämatologie (EHA) in Wien vorgestellt und als ein Highlight des Kongresses ausgewählt.
Gesundheitliche Belastung
„Für viele ältere AML-Patienten ist eine intensive Chemotherapie gesundheitlich eher eine Belastung als eine langfristige Hilfe. Mit unserer Studie zeigen wir, dass es eine schonendere Alternative gibt“, erklärt Studienleiter Prof. Dr. Michael Lübbert, Oberarzt an der Klinik für Innere Medizin I des Universitätsklinikums Freiburg (Ärztlicher Direktor: Prof. Dr. Justus Duyster), die Notwendigkeit einer weniger aggressiven Therapieform.
Schonende Therapie ohne langen stationären Krankenhausaufenthalt
Insgesamt wurden 606 Patienten an 54 Standorten in acht Ländern Europas behandelt. In der Studie kam der epigenetisch aktive Wirkstoff Decitabin zum Einsatz. Dieser zerstört im Gegensatz zu Medikamenten der herkömmlichen Chemotherapie die Krebszellen nicht sofort, sondern beeinflusst primär, welche Gene in den Krebszellen abgelesen werden und verhindert so ihre krankhafte Vermehrung. „Unter der besser verträglichen Therapie können die Patienten oft ihr ganz normales Leben führen, ohne belastende stationäre Krankenhausaufenthalte. Das ist für uns, neben der Heilung, ein ganz wichtiges Ziel“, so Lübbert. Die Entwicklung neuer epigenetischer Therapien und die Erforschung der entsprechenden grundlegenden biologischen Vorgänge gehören zu den Forschungsschwerpunkten der Medizinischen Fakultät der Universität Freiburg, zum Beispiel im Sonderforschungsbereich 992, MEDEP.
AML: Aggressiver Blutkrebs bei Älteren
Nur ein kleiner Teil der AML-Patienten, die über 60 Jahre alt sind, überlebt die Diagnose mehr als fünf Jahre: entweder, weil die alleinige Standard-Chemotherapie nicht zur Heilung führt, oder weil sie wegen des schlechten Gesundheitszustands der Patienten gar nicht erst angewendet werden kann. Als am erfolgversprechendsten gilt bislang eine Kombination aus intensiver Chemotherapie und nachfolgender Blutstammzell-Transplantation. Diese wird am Universitätsklinikum Freiburg seit Jahren unter Prof. Dr. Jürgen Finke, dem Leiter der Sektion Allogene Stammzelltransplantation der Klinik für Innere Medizin I des Universitätsklinikums Freiburg, durchgeführt.
In der nun veröffentlichten klinischen Studie wurden die Patienten zu Beginn entweder zehn Tage lang mit Decitabin oder mit der Standard-Chemotherapie behandelt. Im Anschluss wurde eine Stammzelltransplantation durchgeführt. War dies nicht möglich, erhielten die Patienten entweder weiterhin Decitabin oder bis zu drei weitere Chemotherapie-Kurse. „Wir konnten mit dieser Studie eine Therapie-Sequenz etablieren, die aufgrund ihrer besseren Verträglichkeit der klassischen intensiven Chemotherapie bei älteren AML-Patienten überlegen sein könnte“, sagt Lübbert. In Bezug auf die Überlebensrate nach vier Jahren unterschieden sich Chemotherapie und Decitabin nicht grundlegend (30 %, 26 %). Schwere Nebenwirkungen traten bei Decitabin jedoch deutlich seltener auf (3,6 %) als bei Chemotherapie (6,4 %).